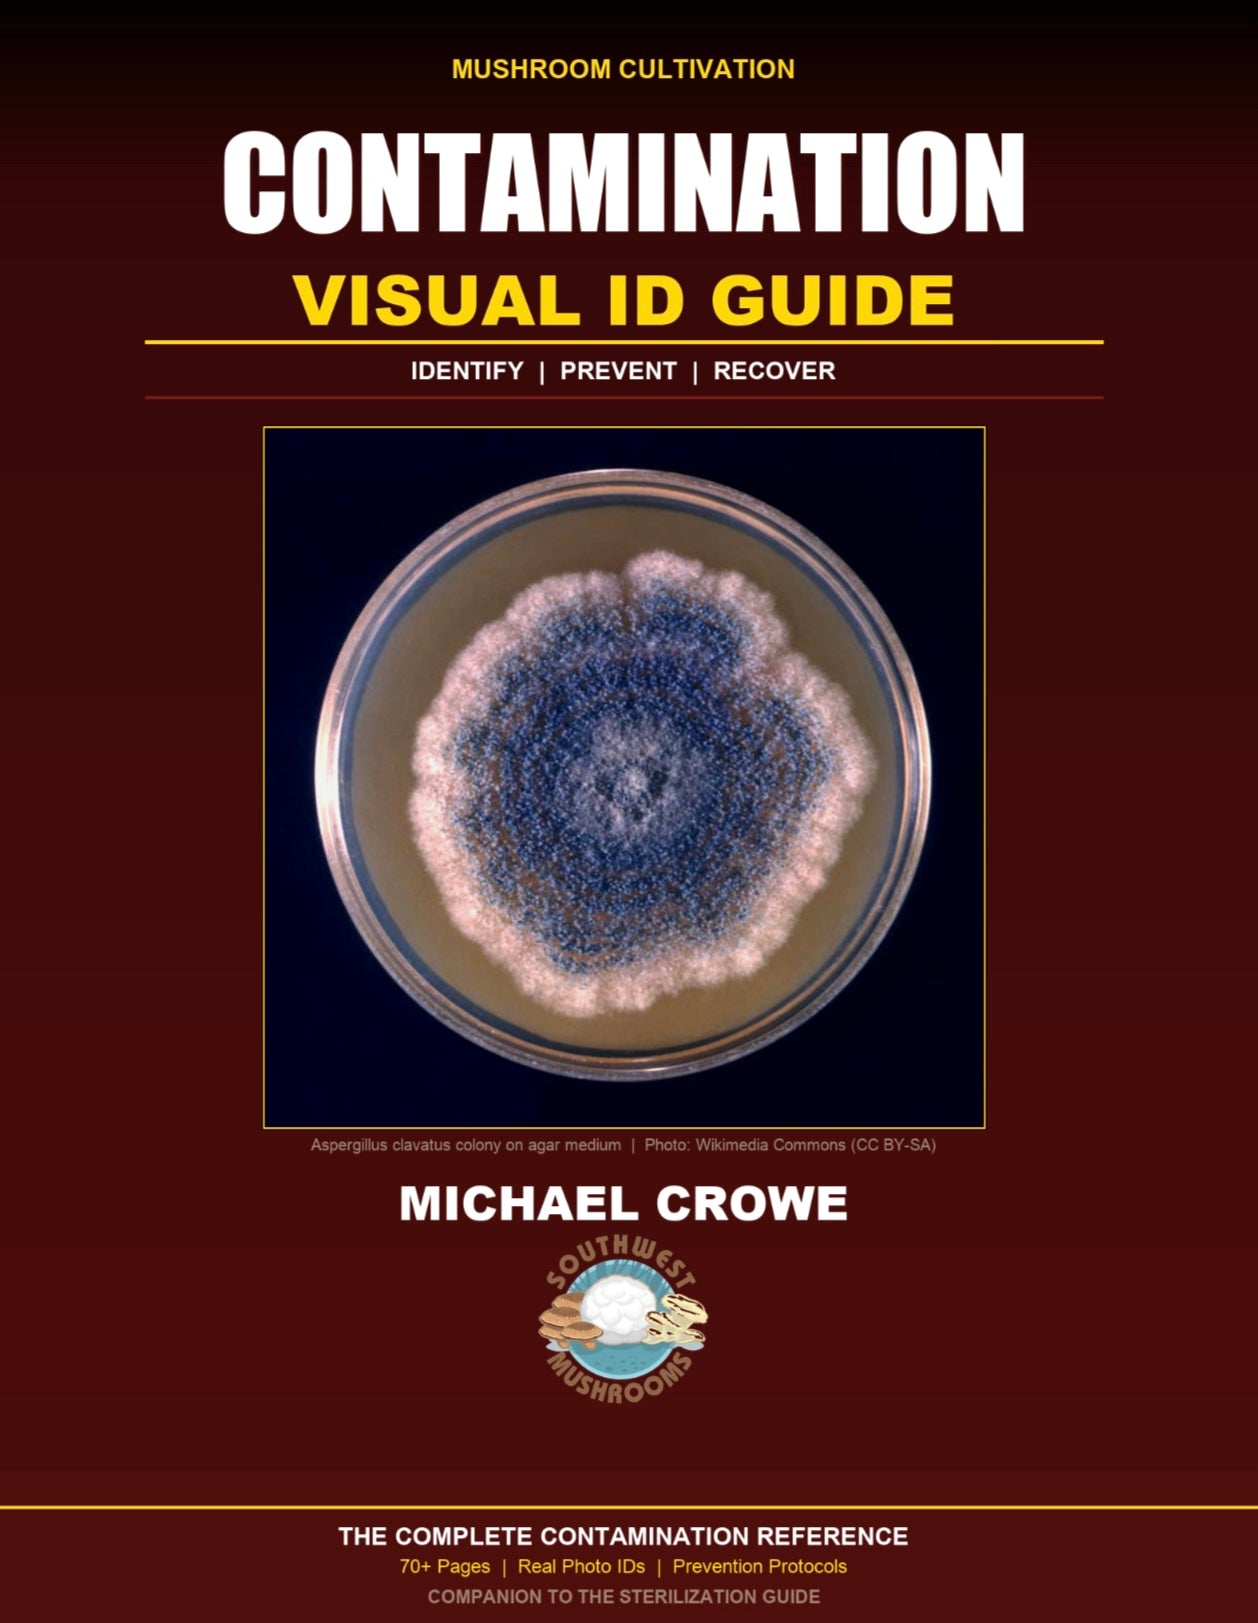
Contamination Visual ID Guide

-
150 Gallon Mushroom Sterilizer -
Blue Oyster California Mycelium Liquid Culture 10ml -
Blue Oyster Commercial Liquid Culture -
Blue Oyster Mushroom Grow Kit -
Brain Stack Nootropic Blend -
Commercial Cultivation Starter Program -
Contamination Visual ID Guide -
Cordyceps High Potency Culture -
Cordyceps Performance Tincture -
Culture Expansion Pack 28 Premium Strains -
Dad hat -
Dried Morels per oz -
Essential Guide to Mushroom Species: Grow Shiitake, Oyster, Lion’s Mane, and More! -
Five Defenders Immune Blend -
Golden Oyster Premium Culture -
Italian Oyster Mycelium Grain Spawn -
Journey Into Mycology - Audiobook -
Journey Into Mycology - Complete Ebook -
King Oyster Commercial Culture -
Lion's Mane Cognitive Tincture -
Lion's Mane Mushroom Grow Kit -
Lion's Mane Premium Liquid Culture -
Lions Mane HE3 Mycelium Liquid Culture 10ml -
Lions Mane Mycelium Grain Spawn
Your cart is empty
Have an account? Log in to check out faster.